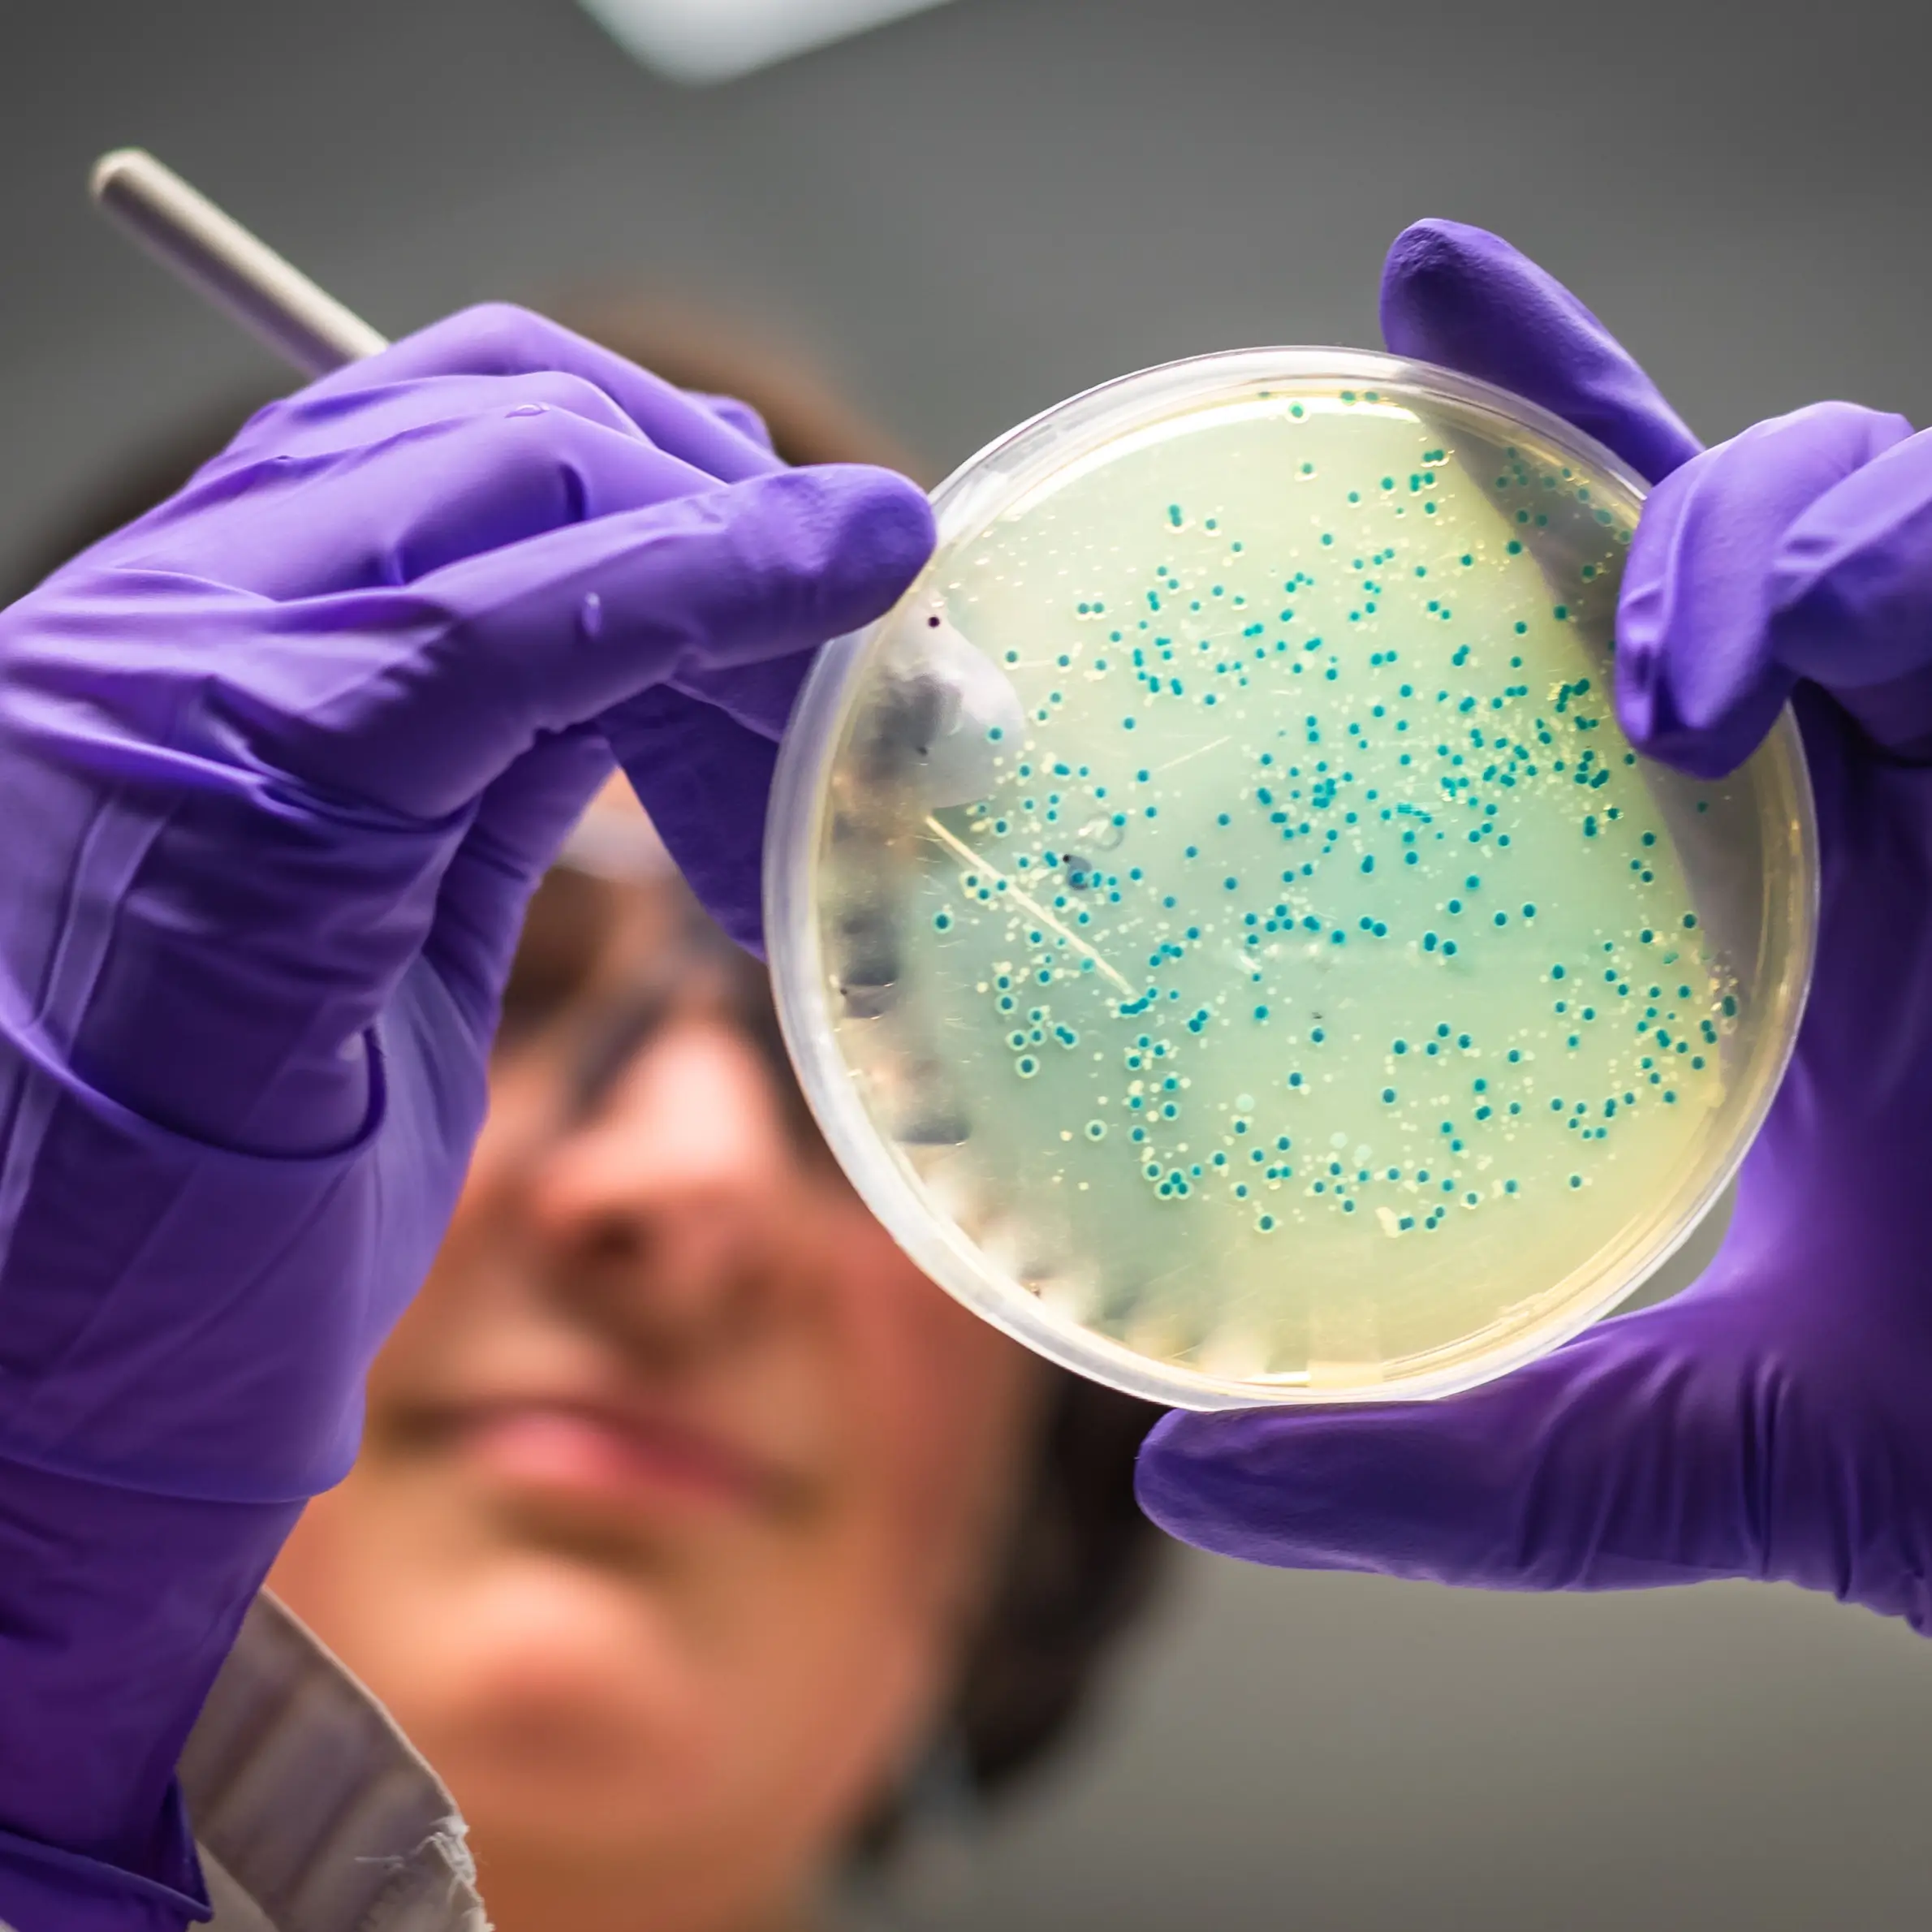
Bellingham Microbiome Testing at The Local Dentist

Here are 5 questions you should ask before treating sleep apnea with Oral Appliance Therapy!
Add your info and we'll send you the top 5 questions you should ask before treating sleep apnea with oral appliance therapy!
See real patient success stories.